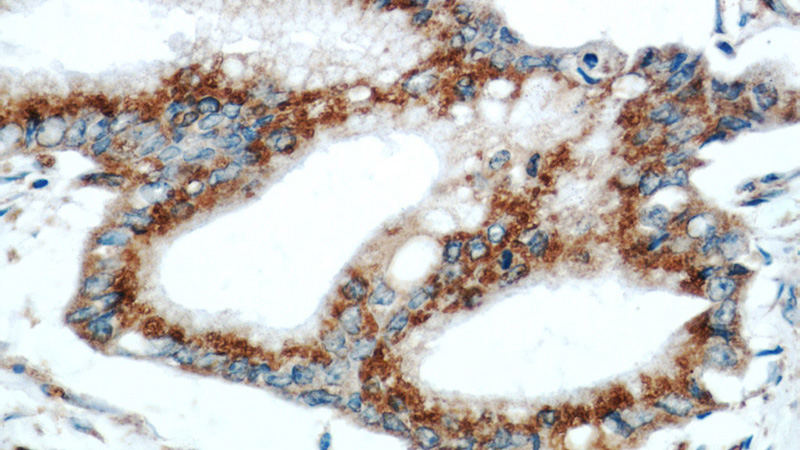
Immunohistochemical of paraffin-embedded human pancreas cancer using Catalog No:111221(GRP78,BIP antibody) at dilution of 1:50 (under 40x lens)

-
Product Name
GRP78/BIP antibody
- Documents
-
Description
GRP78/BIP Rabbit Polyclonal antibody. Positive FC detected in HeLa cells. Positive IHC detected in human pancreas cancer tissue, human brain tissue, human breast cancer tissue, human colon cancer tissue, mouse heart tissue. Positive IF detected in HepG2 cells. Positive IP detected in MCF-7 cells. Positive WB detected in HepG2 cells, BxPC-3 cells, HeLa cells, MCF7 cells, rat liver tissue, TN treated Hela cells. Observed molecular weight by Western-blot: 78 kDa
-
Tested applications
ELISA, WB, IP, IF, FC, IHC
-
Species reactivity
Human, Mouse, Rat; other species not tested.
-
Alternative names
BIP antibody; GRP 78 antibody; GRP78 antibody; HSP A5 antibody; HSPA5 antibody; MIF2 antibody
- Immunogen
-
Isotype
Rabbit IgG
-
Preparation
This antibody was obtained by immunization of GRP78/BIP recombinant protein (Accession Number: NM_005347). Purification method: Antigen affinity purified.
-
Clonality
Polyclonal
-
Formulation
PBS with 0.1% sodium azide and 50% glycerol pH 7.3.
-
Storage instructions
Store at -20℃. DO NOT ALIQUOT
-
Applications
Recommended Dilution:
WB: 1:500-1:5000
IP: 1:500-1:5000
IHC: 1:20-1:200
IF: 1:10-1:100
-
Validations

HepG2 cells were subjected to SDS PAGE followed by western blot with Catalog No:111221(GRP78,BIP antibody) at dilution of 1:1000

Immunohistochemical of paraffin-embedded human pancreas cancer using Catalog No:111221(GRP78,BIP antibody) at dilution of 1:50 (under 10x lens)
Immunohistochemical of paraffin-embedded human pancreas cancer using Catalog No:111221(GRP78,BIP antibody) at dilution of 1:50 (under 40x lens)

Immunofluorescent analysis of HepG2 cells using Catalog No:111221(GRP78,BIP Antibody) at dilution of 1:25 and Rhodamine-Goat anti-Rabbit IgG

1X10^6 HeLa cells were stained with 0.2ug GRP78,BIP antibody (Catalog No:111221, red) and control antibody (blue). Fixed with 4% PFA blocked with 3% BSA (30 min). Alexa Fluor 488-congugated AffiniPure Goat Anti-Rabbit IgG(H+L) with dilution 1:1000.

IP Result of anti-GRP78,BIP (IP:Catalog No:111221, 3ug; Detection:Catalog No:111221 1:1000) with MCF-7 cells lysate 3250ug.
-
Background
GRP78 (HSPA5), also referred to as 'immunoglobulin heavy chain-binding protein' (BiP), is a member of the heat-shock protein-70 (HSP70) family and is involved in the folding and assembly of proteins in the endoplasmic reticulum (ER).It is a constitutively expressed resident protein of the ER in all eukaryotic cells. Recently it has been reported that GRP78 is associated with apoptosis or inhibition of cancer cell growth.
-
References
- Gao XC, Zhou CJ, Zhou ZR. Co-chaperone HSJ1a dually regulates the proteasomal degradation of ataxin-3. PloS one. 6(5):e19763. 2011.
- Liu CI, Chen CC, Chen JC. Proteomic analysis of anti-tumor effects of 11-dehydrosinulariolide on CAL-27 cells. Marine drugs. 9(7):1254-72. 2011.
- Kim HJ, Kang UB, Lee H. Profiling of differentially expressed proteins in stage IV colorectal cancers with good and poor outcomes. Journal of proteomics. 75(10):2983-97. 2012.
- Hill R, Li Y, Tran LM. Cell intrinsic role of COX-2 in pancreatic cancer development. Molecular cancer therapeutics. 11(10):2127-37. 2012.
- Zhu Z, Xu W, Dai J. The alteration of protein profile induced by cigarette smoking via oxidative stress in mice epididymis. The international journal of biochemistry & cell biology. 45(3):571-82. 2013.
- Ho KY, Yeh TS, Huang HH. Upregulation of phosphorylated HSP27, PRDX2, GRP75, GRP78 and GRP94 in acquired middle ear cholesteatoma growth. International journal of molecular sciences. 14(7):14439-59. 2013.
- Xue J, Wei J, Dong X. ABCG1 deficiency promotes endothelial apoptosis by endoplasmic reticulum stress-dependent pathway. The journal of physiological sciences : JPS. 63(6):435-44. 2013.
- Dong D, Zhang S, Yin L. Protective effects of the total saponins from Rosa laevigata Michx fruit against carbon tetrachloride-induced acute liver injury in mice. Food and chemical toxicology : an international journal published for the British Industrial Biological Research Association. 62:120-30. 2013.
Related Products / Services
Please note: All products are "FOR RESEARCH USE ONLY AND ARE NOT INTENDED FOR DIAGNOSTIC OR THERAPEUTIC USE"
